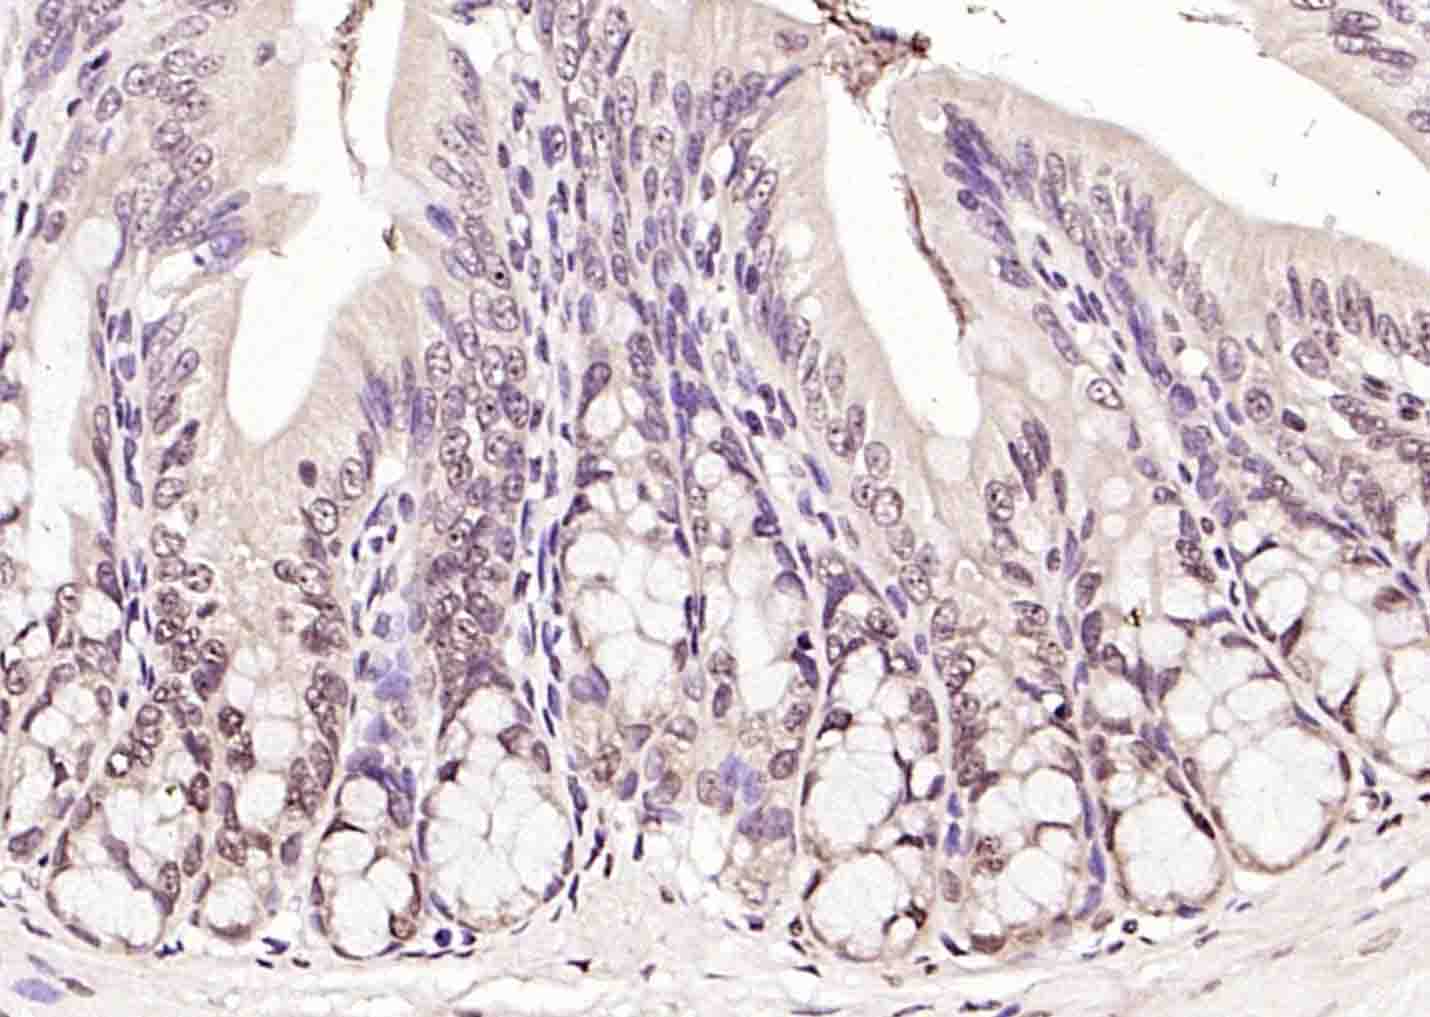
RNA polymerase II Rabbit pAb(b

相关产品推荐更多 >

EAAT1 Rabbit pAb, APC-Cy5.5 conjugated(bs-1003R-APC-Cy5.5)-100ul
¥2980
CD24 Rabbit pAb(bs-23867R)-50ul/100ul/200ul
¥1180
EAAT4 Rabbit pAb(bs-13046R)-50ul/100ul/200ul
¥1180
Cytokeratin 1 Rabbit pAb, APC-Cy5.5 conjugated(bs-1244R-APC-Cy5.5)-100ul
¥2980
PTPRN2 Rabbit pAb, Biotin conjugated(bs-20830R-Bio)-100ul
¥2980
万千商家帮你免费找货
0 人在求购买到急需产品
- 详细信息
- 文献和实验
- 技术资料
- 应用范围:
产品信息以Bioss网站为准
- 规格:
50ul/100ul/200ul
| 规格: | 50ul | 产品价格: | ¥1180.0 |
|---|---|---|---|
| 规格: | 100ul | 产品价格: | ¥1980.0 |
| 规格: | 200ul | 产品价格: | ¥2800.0 |
| 产品编号 | bs-6972R |
| 英文名称 | RNA polymerase II Rabbit pAb |
| 中文名称 | RNA聚合酶II抗体 |
| 英文别名 | POLR2A; POLR2; DNA directed RNA polymerase II A; DNA-directed RNA polymerase II largest subunit; DNA-directed RNA polymerase II subunit A; RPB1_HUMAN. |
| 产品应用 | IHC-P=1:100-500, IHC-F=1:100-500, IF=1:100-500 Not yet tested in other applications. |
| 交叉反应 | Mouse, Rat (Human, Dog, Pig, Cow, Horse) |
| 抗体来源 | Rabbit |
| 免疫原 | KLH conjugated synthetic peptide derived from human Pol II/RNA polymerase II |
| 亚型 | IgG |
| 性状 | Liquid |
| 纯化方法 | affinity purified by Protein A |
| 克隆类型 | Polyclonal |
| 理论分子量 | 217 kDa |
| 浓度 | 1mg/ml |
| 储存液 | 0.01M TBS (pH7.4) with 1% BSA, 0.02% Proclin300 and 50% Glycerol. |
| 研究领域 | Epigenetics and Nuclear Signaling > Transcription > Polymerase associated factors > Pol II Transcription Epigenetics and Nuclear Signaling > Transcription > Polymerase associated factors > Pol II Transcription > Polymerase Epigenetics and Nuclear Signaling > Transcription > RNA polymerase |
| 亚基 | Component of the RNA polymerase II (Pol II) complex consisting of 12 subunits. The phosphorylated C-terminal domain interacts with FNBP3 and SYNCRIP. Interacts with SAFB/SAFB1. Interacts with CCNL1 and MYO1C (By similarity). Interacts with CCNL2 and SFRS19. Component of a complex which is at least composed of HTATSF1/Tat-SF1, the P-TEFb complex components CDK9 and CCNT1, RNA polymerase II, SUPT5H, and NCL/nucleolin. Interacts with PAF1. Interacts (via C-terminus) with FTSJD2, CTDSP1 and SCAF8. Interacts via the phosphorylated C-terminal domain with WDR82 and with SETD1A and SETD1B only in the presence of WDR82. Interacts with ATF7IP. When phosphorylated at 'Ser-5', interacts with MEN1; the unphosphorylated form, or phosphorylated at 'Ser-2' does not interact. Interacts with DDX5. |
| 亚细胞定位 | Nucleus. |
| 翻译后修饰 | Dephosphorylated by the protein phosphatase CTDSP1. [PTM] Ubiquitinated by WWP2 leading to proteasomal degradation (By similarity). [PTM] Methylated at Arg-1810 by CARM1. Methylation occurs only when the CTD is hypophosphorylated, and phosphorylation at Ser-1805 and Ser-1808 prevent methylation (in vitro). It is assumed that methylation occurs prior to phosphorylation and transcription initiation. CTD methylation may facilitate the expression of select RNAs. |
| 相似性 | Belongs to the RNA polymerase beta' chain family. |
| 功能 | DNA-dependent RNA polymerase catalyzes the transcription of DNA into RNA using the four ribonucleoside triphosphates as substrates. Largest and catalytic component of RNA polymerase II which synthesizes mRNA precursors and many functional non-coding RNAs. Forms the polymerase active center together with the second largest subunit. Pol II is the central component of the basal RNA polymerase II transcription machinery. It is composed of mobile elements that move relative to each other. RPB1 is part of the core element with the central large cleft, the clamp element that moves to open and close the cleft and the jaws that are thought to grab the incoming DNA template. At the start of transcription, a single stranded DNA template strand of the promoter is positioned within the central active site cleft of Pol II. A bridging helix emanates from RPB1 and crosses the cleft near the catalytic site and is thought to promote translocation of Pol II by acting as a ratchet that moves the RNA-DNA hybrid through the active site by switching from straight to bent conformations at each step of nucleotide addition. During transcription elongation, Pol II moves on the template as the transcript elongates. Elongation is influenced by the phosphorylation status of the C-terminal domain (CTD) of Pol II largest subunit (RPB1), which serves as a platform for assembly of factors that regulate transcription initiation, elongation, termination and mRNA processing. Acts as a RNA-dependent RNA polymerase when associated with small delta antigen of Hepatitis delta virus, acting both as a replicate and transcriptase for the viral RNA circular genome. |
| 保存条件 | Shipped at 4℃. Store at -20℃ for one year. Avoid repeated freeze/thaw cycles. |
| 注意事项 | This product as supplied is intended for research use only, not for use in human, therapeutic or diagnostic applications. |
| 背景资料 | DNA-dependent RNA polymerase catalyzes the transcription of DNA into RNA using the four ribonucleoside triphosphates as substrates. Largest and catalytic component of RNA polymerase II which synthesizes mRNA precursors and many functional non-coding RNAs. Forms the polymerase active center together with the second largest subunit. Pol II is the central component of the basal RNA polymerase II transcription machinery. It is composed of mobile elements that move relative to each other. RPB1 is part of the core element with the central large cleft, the clamp element that moves to open and close the cleft and the jaws that are thought to grab the incoming DNA template. At the start of transcription, a single stranded DNA template strand of the promoter is positioned within the central active site cleft of Pol II. A bridging helix emanates from RPB1 and crosses the cleft near the catalytic site and is thought to promote translocation of Pol II by acting as a ratchet that moves the RNA-DNA hybrid through the active site by switching from straight to bent conformations at each step of nucleotide addition. During transcription elongation, Pol II moves on the template as the transcript elongates. Elongation is influenced by the phosphorylation status of the C-terminal domain (CTD) of Pol II largest subunit (RPB1), which serves as a platform for assembly of factors that regulate transcription initiation, elongation, termination and mRNA processing. Acts as a RNA-dependent RNA polymerase when associated with small delta antigen of Hepatitis delta virus, acting both as a replicate and transcriptase for the viral RNA circular genome. |
| 应用 | 推荐稀释比例 |
| {IHC-P} | {1:100-500} |
| {IHC-F} | {1:100-500} |
| {IF} | {1:100-500} |

Antigen retrieval: citrate buffer ( 0.01M, pH 6.0 ), Boiling bathing for 15min; Block endogenous peroxidase by 3% Hydrogen peroxide for 30min; Blocking buffer (normal goat serum,C-0005) at 37℃ for 20 min;
Incubation: Anti-POLR2 Polyclonal Antibody, Unconjugated(bs-6972R) 1:200, overnight at 4°C, followed by conjugation to the secondary antibody(SP-0023) and DAB(C-0010) staining

风险提示:丁香通仅作为第三方平台,为商家信息发布提供平台空间。用户咨询产品时请注意保护个人信息及财产安全,合理判断,谨慎选购商品,商家和用户对交易行为负责。对于医疗器械类产品,请先查证核实企业经营资质和医疗器械产品注册证情况。
文献和实验[IF={{ 6.117 }}] {Gang Lin. et al. ARID1B blocks methionine-stimulated mTOR activation to inhibit milk fat and protein synthesis in and proliferation of mouse mammary epithelial cells. J NUTR BIOCHEM. 2023 Jan;:109274} {ChIP} {Mouse}
[IF={{ 6.1 }}] {Liping Xie. et al. Methionine Promotes Milk Synthesis through the BRCC36-BRG1-mTOR Signaling Axis in Mammary Epithelial Cells. J AGR FOOD CHEM. 2024;XXXX(XXX):XXX-XXX} {ChIP} {Mouse}
[IF={{ 6.1 }}] {Hao Qi. et al. Methionine and Leucine Promote mTOR Gene Transcription and Milk Synthesis in Mammary Epithelial Cells through the eEF1Bα-UBR5-ARID1A Signaling. J AGR FOOD CHEM. 2024;XXXX(XXX):XXX-XXX} {ChIP} {Bovine}
[IF={{ 6.048 }}] {Hao Qi. et al. Methionine and leucine induce ARID1A degradation to promote mTOR expression and milk synthesis in mammary epithelial cells. J Nutr Biochem. 2021 Nov;:108924} {IP} {Cow}
[IF={{ 4.26 }}] {Dou et al. STMN1 Promotes Progesterone Production Via StAR Up-regulation in Mouse Granulosa Cells. (2016) Sci.Re. 6:26691} {ChIP} {Mouse}
An RNA Polymerase II In Vitro Transcription System
A great deal of attention in recent years has been focused on the mechanisms governing transcription. Repression and/or activation of specific genes, or sets of genes, represents a key regulatory step in such diverse processes as cell growth
Profiling RNA Polymerase II Using the Fast Chromatin Immunoprecipitation Method
polymerase II (Pol II) chromatin immunoprecipitation (ChIP) is a simpler alternative to determine the transcription rate of genes. Moreover, this approach provides more information about the transcriptional regulation of a gene than nuclear run-on. The power
RNA polymerase II (Pol II) plays a crucial role in eukaryotic biology since it is necessary for the expression of all protein-coding genes as well as most microRNAs and several small nuclear RNAs. Pol II is specifically recruited to core
技术资料暂无技术资料 索取技术资料






